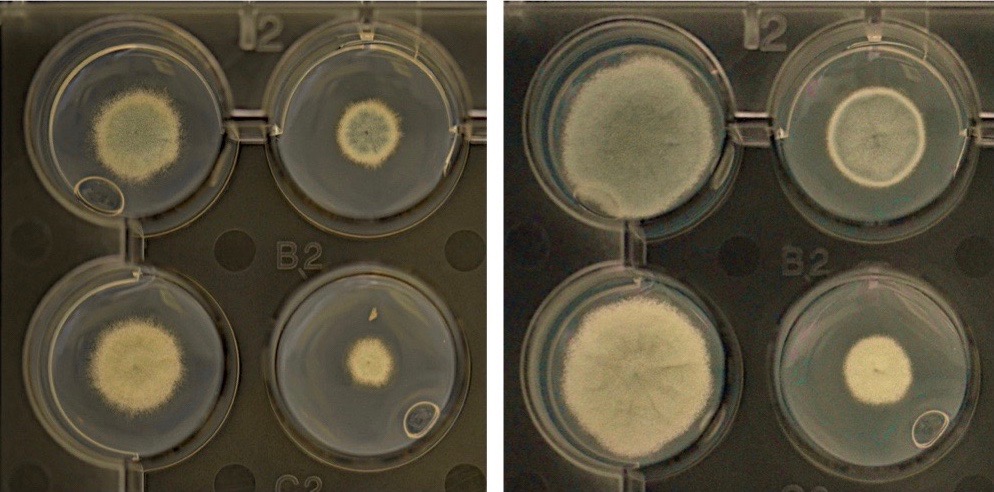
Graessle-2a-(1)

Structure & Function of Chromatin: Filamentous Fungi
|
Histone modifying enzymes as virulence factors, drug targets and regulators of small bioactive molecules of filamentous fungi
In eukaryotic cells, the readout of the genetic information is significantly controlled by structural changes of chromatin. Covalent modifications of DNA and core-histone proteins, the building blocks of nucleosomes, are primarily responsible for genome-wide or localized chromatin alterations. In response to cellular or environmental signals, these modifications affect a variety of regulatory processes during growth, differentiation and development, metabolism, diseases, and abiotic and biotic stress.
Within the last decade, we have deleted numerous histone modifying enzymes in pathogenic and non-pathogenic filamentous fungi and have analyzed the corresponding mutants with regard to pathogenicity, production of fungal metabolites and fitness under different growth conditions.
Whereas some deletions show only negligible effects, others significantly impact viability, production of important secondary metabolites such as antibiotics and toxins or affect pathogenicity of causative fungi. A further characterization of histone modifying enzymes and the elucidation of their roles as regulators of metabolites, as virulence factors or targets of antifungal substances is one goal of our current research. Moreover, we perform proteomic analyses in order to identify novel substrates of these modifiers, currently in particular of histone deacetylases (HDACs) and arginine methyltransferases (PRMTs), respectively.
Histone methylation in filamentous fungi

Associate Professor
Gerald Brosch
phone: +43/512/9003-70211
email: gerald.brosch@i-med.ac.at
CV
Histone methylation in filamentous fungi
(principal investigator: Gerald Brosch)
DNA of the eukaryotic nucleus is organized by histones, small basic proteins which are subject to reversible, postsynthetic modifications, such as phosphorylation, acetylation and methylation. During the past years it became evident that a complex interplay between these modifications occurring on the histone tails exist which are all involved in gene-specific regulation. Histone methylation is carried out by histone methyltransferases (HMTs) which are classified due to their substrate specificity. Whereas protein arginine methyltransferases (PRMTs) can use arginine residues on H3 and H4 as substrate, SET domain containing HMTs catalyse the methylation of lysines on the same histone molecules. The recent identification and analysis of different HMTs revealed enzymes that stimulate either gene repression or gene activation, depending on the residue being modified and the type of methylation being introduced. The long-term objective of our research is to investigate the functional role of protein methylation in filamentous fungi. We are performing our studies in the model organism A. nidulans since this fungus is not only well suited to study general mechanisms of chromatin regulation, but, in addition allows to explore the significance of chromatin modifications for fungal virulence (e.g. aspergillosis) and secondary metabolism (e.g. production of antibiotics, immunosuppressants, toxins). We have identified three distinct PRMTs which all exhibit histone methyltransferase activity in vitro and in vivo. One of these proteins, termed RmtB, has an exceptional position because it displays both enzymatic and structural properties that are different from other known PRMTs. To study the functional role of PRMTs in A. nidulans we are currently deleting the corresponding PRMT genes by targeted gene replacement and are analysing putative growth defects of rmtA/ rmtB, and rmtC deletion mutants under various growth conditions. These studies will be completed by the generation of double and triple mutant strains and the concomitant investigation of physiological and developmental effects. Finally, the analysis of global gene expression patterns, the study of effects of rmtA, rmtB, and rmtC deletion on the regulation of genes involved in secondary metabolism pathways, and the identification of novel substrate proteins of PRMTs will help to clarify the role of arginine methylation in Aspergillus.
Selected Publications
- Karahoda, B., Pardeshi, L., Ulas, M., Dong, Z., Shirgaonkar, N., Guo, S., Wang, F., Tan, K., Sarikaya-Bayram, Ö., Bauer, I., Dowling, P., Fleming, A.B., Pfannenstiel, B.T., Luciano-Rosario, D., Berger, H., Graessle, S., Alhussain, M.M., Strauss, J., Keller, N.P., Wong, K.H., Bayram, Ö. (2022). The KdmB-EcoA-RpdA-SntB chromatin complex binds regulatory genes and coordinates fungal development with mycotoxin synthesis. Nucleic Acids Res. doi: 10.1093/nar/gkac744
- Bauer, I. and Graessle, S. (2021). Fungal Lysine Deacetylases in Virulence, Resistance, and Production of Small Bioactive Compounds. Genes 12,1470. doi: 10.3390/genes12101470
- Bauer, I., Gross S., Merschak, P., Kremser, L., Karahoda, B., Sarikaya Bayram, Ö., Abt, B., Binder, U., Gsaller, F., Lindner, H., Bayram, Ö., Brosch, G. and Graessle, S. (2020). RcLS2F – A Novel Fungal Class 1 KDAC Co-repressor Complex in Aspergillus nidulans. Front. Microbiol. 11:43. doi:10.3389/fmicb.2020.00043
- Bauer, I., Misslinger, M., Shadkchan, Y., Dietl, A.M., Petzer, V., Orasch, T., Abt, B., Graessle, S., Osherov, N. and Haas, H. (2019). The Lysine Deacetylase RpdA Is Essential for Virulence in Aspergillus fumigatus. Front. Microbiol 10:2773. doi: 10.3389/fmicb.2019.02773
- Bauer, I., Lechner, L., Pidroni, A., Petrone, A., Merschak, P., Lindner, H., Kremser, L., Graessle, S., Golderer, G., Allipour, S. and Brosch, G. (2019). Type I and II PRMTs regulate catabolic as well as detoxifying processes in Aspergillus nidulans. Fungal Genet and Biol. 129, 86-100 doi:10.1016/j.fgb.2019.05.006
- Bauer, I., Pidroni, A., Bayram, Ö., Brosch, G., Graessle, S. (2019). Single-Step Enrichment of a TAP-Tagged Histone Deacetylase of the Filamentous Fungus Aspergillus nidulans for Enzymatic Activity Assay. J. Vis. Exp. 147: e59527. doi:10.3791/59527
- Pidroni A., Faber B., Brosch G., Bauer I. and Graessle S. (2018). A Class 1 Histone Deacetylase as Major Regulator of Secondary Metabolite Production in Aspergillus nidulans. Front. Microbiol. 9:2212. doi:10.3389/fmicb.2018.02212
- Bauer I., Varadarajan D., Pidroni A., Gross S., Vergeiner S., Faber B., Herrmann M., Tribus M., Brosch G., Graessle S. (2016). A class 1 histone deacetylase with potential as an antifungal target. mBio 7(6):e00831-16. doi: 10.1128%2FmBio.00831-16
- Wang, L., Kofler, M., Brosch, G., Melesina, J., Sippl, W., Martinez, E.D., Easmon, J. (2015). 2-Benzazolyl-4-Piperazin-1-Ylsulfonylbenzenecarbohydroxamic Acids as Novel Selective Histone
- Deacetylase-6 Inhibitors with Antiproliferative Activity. PLoS One 10(12).
- Hagelkruys, A., Lagger, S., Krahmer, J., Leopoldi, A., Artaker, M., Pusch, O., Zezula, J., Weissmann, S., Xie, Y., Schöfer, C., Schlederer, M., Brosch, G., Matthias, P., Selfridge, J., Lassmann, H., Knoblich, J.A., Seiser, C. (2014). A single allele of Hdac2 but not Hdac1 is sufficient for normal mouse brain development in the absence of its paralog. Development. 141(3), 604-16.
- Valente, S., Trisciuoglio, D., De Luca, T., Nebbioso, A., Labella, D., Lenoci, A., Bigogno, C., Dondio, G., Miceli, M., Brosch, G., Del Bufalo, D., Altucci, L., Mai, A. (2014). 1,3,4-oxadiazole-containing histone deacetylase inhibitors: anticancer activities in cancer cells. J Med Chem. 57(14), 6259-65.
- Winter, M., Moser, M., Meunier, D., Fischer, C., Machat, G., Mattes, K., Lichtenberger, B., Brunmeir, R., Weissmann, S., Murko, C., Humer, C., Meischel, T., Brosch, G., Matthias, P., Sibilia, M., Seiser, C. (2013). Divergent roles of HDAC1 and HDAC2 in the regulation of epidermal development and tumorigenesis. The EMBO Journal , 1-16.
- Valente S, Tardugno M, Conte M, Cirilli R, Perrone A, Ragno R, Simeoni S, Tramontano A, Massa S, Nebbioso A, Miceli M, Franci G, Brosch G, Altucci L, Mai A. (2011). Novel Cinnamyl Hydroxyamides and 2-Aminoanilides as Histone Deacetylase Inhibitors: Apoptotic Induction and Cytodifferentiation Activity. Chem. Med. Chem., 6(4),698-712.
- Castellano, S., Milite, C., Ragno, R., Simeoni, S., Mai, A., Limongelli, V., Novellino, E., Bauer, I., Brosch, G., Spannhoff, A., Cheng, D., Bedford, M.T., Sbardella, G. (2010). Design, synthesis and biological evaluation of carboxy analogues of arginine methyltransferase inhibitor 1 (AMI-1). Chem.Med.Chem. 5(3), 398-414.
- Bauer, I., Graessle, S., Loidl, P., Hohenstein, K., Brosch, G. (2010). Novel insights into the functional role of three protein arginine methyltransferases in Aspergillus nidulans. Fungal Genet Biol. 47(6), 551-561. doi: 10.1016/j.fgb.2010.03.006
- Tribus, M., Bauer, I., Galehr, J., Rieser, G., Brosch, G., Loidl, P., Trojer, P., Haas, H. and Graessle, S. (2010). A novel motif in fungal class 1 histone deacetylases is essential for growth and development of Aspergillus. Molecular Biology of the Cell Vol. 21, 345-353. doi: 10.1091/mbc.E09-08-0750
- Mai A, Valente S, Nebbioso A, Simeoni S, Ragno R, Massa S, Brosch G, De Bellis F, Manzo F, Altucci L. (2009). New pyrrole-based histone deacetylase inhibitors: binding mode, enzyme- and cell-based investigations.Int J Biochem Cell Biol. 41(1):235-47.
- Mai A, Cheng D, Bedford MT, Valente S, Nebbioso A, Perrone A, Brosch G, Sbardella G, De Bellis F, Miceli M, Altucci L. (2008). epigenetic multiple ligands: mixed histone/protein methyltransferase, acetyltransferase, and class III deacetylase (sirtuin) inhibitors.J Med Chem. 51(7):2279-90.
- Mai, A., Valente, S., Cheng, D., Nebbioso, A., Perrone, A., Brosch, G., Sbardella, G., Miceli, M., Altucci, L. & Bedford, M.T. (2008). Epigenetic Multiple Ligands: Mixed Histone/Protein Methyltransferase, Acetyltransferase, and Class III Deacetylase (Sirtuin) Inhibitors. J. Med. 51(7):2279-90.
- Brosch, G., Loidl, P. & Graessle, S. (2008). Histone Modifications and Chromatin Dynamics: A Focus on Filamentous Fungi. FEMS Microbiol. Rev. 32, 409-439.
- Ragno, R., Simeoni, S., Rotili, D., Caroli, A., Botta, G., Brosch, G., Massa, S., Mai, A. (2008). Class II-selective histone deacetylase inhibitors. Part 2: Alignment-independent GRIND 3-D QSAR, homology and docking studies. Eur. J. Med. Chem. 43, 621-632.
- Mai, A., Valente, S., Rotili, D., Massa, S., Botta, G., Brosch, G., Miceli, M., Nebbioso, A. & Altucci, L. (2007). Novel pyrrole-containing histone deacetylase inhibitors endowed with cytodifferentiation activity. Int. J. Biochem. Cell Biol. 39, 1510-1522.
- Spannhoff, A., Machmur, R., Heinke, R., Trojer, P., Bauer, I., Brosch, G., Schule, R., Hanefeld, W., Sippl, W. & Jung, M. (2007). A novel arginine methyltransferase inhibitor with cellular activity. Bioorg. Med. Chem. Lett. 17, 4150-4153.
- Mai, A., Jelicic, K., Rotili, D., Di Noia, A., Alfani, E., Valente, S., Altucci, L., Nebbioso, A., Massa, S., Galanello, R., Brosch, G., Migliaccio, A.R. & Migliaccio, G. (2007). Identification of two New Synthetic Histone Deacetylase Inhibitors that Modulate Globin Gene Expression in Erythroid Cells from Normal Donors and Thalassemic Patients. Mol. Pharmacol. 72, 1111-1123.
- Shwab, E.K., Bok, JW., Tribus, M., Galehr, J., Graessle, S. and Keller, N. (2007). Histone deacetylase activity regulates chemical diversity in Aspergillus nidulans. Euk. Cell 9, 1656-1664.
- Spannhoff, A., Heinke, R., Bauer, I., Trojer, P., Metzger, E., Gust, R., Schuele, R., Brosch, G., Sippl, W. and Jung, M. (2007). Target-based approach to inhibitors of histone arginine methyltransferases. J. Med. Chem. 50, 2319-2325.
- Mai, A., Valente, S., Cheng, D., Perrone, A., Ragno, R., Simeoni, S., Sbardella, G., Brosch, G., Nebbioso, A., Conte, M., Altucci, L., and Bedford, M.T. (2007). Synthesis and Biological Validation of Novel Synthetic Histone/Protein Methyltransferase Inhibitors. Chem. Med. Chem. 2, 987-991.
- Ragno, R., Simeoni, S., Castellano, S., Vicidomini, C., Mai, A., Caroli, A., Tramontano, A., Bonaccini, C., Trojer, P., Bauer, I., Brosch, G. and Sbardella, G. (2007). Small Molecule Inhibitors of Histone Arginine Methyltransferases: Homology Modeling, Molecular Docking, Binding Mode Analysis and Biological Evaluations. J. Med. Chem. 50, 1241-1253.
- Mai, A., Rotili, D., Massa, S., Brosch, G., Simonetti, G., Passariello, C., Palamara, A. T. (2007). Discovery of uracil-based histone deacetylase inhibitors able to reduce acquired antifungal resistance and trailing growth in Candida albicans. Bioorg. Med. Chem. Lett. 17, 1221-1225.
- Mai, A., Massa, S., Rotili, D., Simeoni, S., Ragno, R., Botta, G., Nebbioso, A., Miceli, M., Altucci, L., & Brosch, G. (2006). Synthesis and biological properties of novel, uracil-containing histone deacetylase inhibitors. J. Med. Chem. 49, 6046-6056
- Mai, A., Massa, S., Valente, S., Simeoni, S., Ragno, R., Bottoni, P., Scatena, R. & Brosch, G. (2006). Aroyl-pyrrolyl hydroxyamides: Influence of pyrrole C4-phenylacetyl substitution on histone deacetylase inhibition Chem.Med.Chem. 1, 225-237.
- Causevic, A., Gentil, M.-V., Delaunay, A., Abu El-Soud, W., Garcia, Z., Pannetier, C., Brignolas, F., Hagege, D. & Maury, S. (2006). Relationship between DNA methylation and histone acetylation levels, cell redox and cell differentiation states in sugarbeet lines Planta 224, 812-827.
- Mai, A., Massa, S., Rotili, D., Pezzi, R., Bottoni, P., Scatena, R., Meraner, J. & Brosch, G. (2005). Exploring the connection unit in the HDAC inhibitor pharmacophore model: Novel uracil-based hydroxamates. Bioorg. Med. Chem. Lett. 15, 4656-4661.
- Mai, A., Massa, S., Pezzi, R., Valente, S., Loidl, P. & Brosch, G. (2005). Synthesis and Biological Evaluation of 2-, 3-, and 4-Acylaminocinnamyl-N-hydroxyamides as Novel Synthetic HDAC Inhibitors. Med. Chem. 1, 245-254.
- Vietor, I., Kurzbauer, R., Brosch, G. & Huber, L.A. (2005). TIS7 regulation of the beta-catenin / TCF-4 target gene OPN is histone deacetylase dependent J. Biol. Chem. 280, 39795-39801.
- Tribus, M., Galehr, J., Trojer, P., Brosch, G., Loidl, P., Marx, F., Haas, H. & Graessle, S. (2005). HdaA, a Major Class 2 Histone Deacetylase of Aspergillus nidulans Affects Growth Under Conditions of Oxidative Stress. Eukaryot. Cell 4, 1736-1745.
- Mai, A., Massa, S., Pezzi, R., Simeoni, S., Rotili, D., Nebbioso, A., Scognamiglio, A., Altucci, L., Loidl, P. & Brosch, G. (2005). Class II (IIa)-selective histone deacetylase inhibitors. 1. Synthesis and biological evaluation of novel (aryloxopropenyl)pyrrolyl hydroxyamides. J. Med. Chem. 48, 3344-3353.
- Vance, K.W., Carreira, S., Brosch, G. & Goding, C.R. (2005). Tbx2 is overexpressed and plays an important role in maintaining proliferation and suppression of senescence in melanomas. Cancer Res. 65, 2260-2268.
- Marx, F., Salvenmoser, W., Kaiserer, L., Graessle, S., Weiler-Gorz, R., Zadra, I. & Oberparleiter, C. (2005). Proper folding of the antifungal protein PAF is required for optimal activity. Res. Microbiol. 156, 35-46.
- Trojer, P., Dangl, M., Bauer, I., Graessle, S., Loidl, P. & Brosch, G. (2004). Histone methyltransferases in Aspergillus nidulans: evidence for a novel enzyme with a unique substrate specificity. Biochemistry 43, 10834-10843.
- Ragno, R., Mai, A., Massa, S., Cerbara, I., Valente, S., Bottoni, P., Scatena, R., Jesacher, F., Loidl, P. and Brosch, G. (2004). 3-(4-Aroyl-1-methyl-1H-pyrrol-2-yl)-N-hydroxy-2-propenamides as a New Class of Synthetic Histone Deacetylase Inhibitors. 3. Discovery of Novel Lead Compounds Through Structure-Based Drug Design and Docking Studies. J. Med. Chem. 47, 1351-1359.
- Mai, A., Massa, S., Cerbara, I., Valente, S., Ragno, R., Bottoni, P., Scatena, R., Loidl, P. and Brosch, G. (2004). 3-(4-Aroyl-1-methyl-1H-2-pyrrolyl)-N-hydroxy-2-propenamides as a new class of synthetic histone deacetylase inhibitors. 2. Effect of pyrrole-C2 and/or -C4 substitutions on biological activity. J. Med. Chem. 47, 1098-1109.
- Mai, A., Massa, S., Pezzi, R., Rotili, D., Loidl, P. and Brosch, G. (2003). Discovery of (aryloxopropenyl)pyrrolyl-hydroxyamides as selective inhibitors of class IIa histone deacetylase homologue HD1-A. J. Med. Chem. 46, 4826-4829.
- Trojer, P., Brandtner, E.M., Brosch, G., Loidl, P., Galehr, J., Linzmaier, R., Haas, H., Mair, K., Tribus, M. and Graessle, S. (2003). Histone deacetylases in fungi: novel members, new facts. Nucl. Acids Res. 31, 3971-3981.
- Mai, A., Massa, S., Ragno, R., Cerbara, I., Jesacher, F., Loidl, P. and Brosch, G. (2003). 3-(4-Aroyl-1-methyl-1H-2-pyrrolyl)-N-hydroxy-2-alkylamides as a New Class of Synthetic Histone Deacetylase Inhibitors. 1. Design, Synthesis, Biological Evaluation, and Binding Mode Studies Performed Through Three Different Docking Procedures. J. Med. Chem. 46, 512-24.
- Baidyaroy, D., Brosch, G., Graessle, S., Trojer, P. and Walton, J.D. (2002). Characterization of inhibitor-resistant histone deacetylase activity in plant-pathogenic fungi. Eukaryotic Cell 1, 538-547.
- Vietor, I., Vadivelu, S.K., Wick, N., Hoffman, R., Cotten, M., Seiser, C., Fialka, Î., Wunderlich, W., Haase, A., Korinkova, G., Brosch, G. and Huber, L.A. (2002). TIS7 interacts with the mammalian SIN3 histone deacetylase complex in epithelial cells. The EMBO Journal 21, 4621-4631.
- Wittich, S., Scherf, H., Xie, C., Brosch, G., Loidl, P., Gerhäuser, C. and Jung, M. (2002). Structure-activity relationships on phenylalanine containing inhibitors of histone deacetylase – In-vitro enzyme inhibition, induction of differentiation and inhibition of proliferation in Friend leukemic cells. J. Med. Chem. 45, 3296-3309.
- Mai, A., Massa, S., Ragno, R., Esposito, M., Sbardella, G., Nocca, G., Scatena, R., Jesacher, F., Loidl, P. and Brosch, G. (2002). Binding Mode Analysis of 3-(4-Benzoyl-1-methyl-1H-2-pyrrolyl)-N-hydroxy-2-propenamide: A New Synthetic Histone Deacetylase Inhibitor Inducing Histone Hyperacetylation, Growth Inhibition, and Terminal Cell Differentiation. J. Med. Chem. 45, 1778-1784.
- Chiocca, S., Kurtev, V., Colombo, R., Boggio, R., Sciurpi, M.T., Brosch, G., Seiser, C., Draetta, G.F. and Cotten, M. (2002). Histone deacetylase 1 inactivation by an adenovirus early gene product. Curr. Biol. 12, 594-598.
- Brosch, G., Dangl, M., Graessle, S., Loidl, A., Trojer, P., Brandtner, E.M., Mair, K., Walton, J.D., Baidyaroy, D. and Loidl, P. (2001). An inhibitor-resistant histone deacetylase in the plant pathogenic fungus Cochliobolus carbonum. Biochemistry 40, 12845-12863.
- Wagner, M., Brosch, G., Zwerschke, W., Seto, E., Loidl, P. and Jansen-Dürr, P., (2001). Histone deacetylases in replicative senescence: Evidence for a senescence-specific form of HDAC-2. FEBS Lett. 499,101-106
- Brosch, G., Baidyaroy, D., Ahn, J., Graessle, S., Wegener, S., Tonukari, N.J., Caballero, O., Loidl, P. and Walton, J.D. (2001). A gene related to yeast HOS2 histone deacetylase affects extracellular depolymerase expression and virulence in a plant pathogenic fungus. Plant Cell 13, 1609-1624.
- Massa, S., Mai, A., Sbardella, G., Esposito, M., Ragno, R., Loidl, P. and Brosch, G. (2001) 3-(4-Aroyl-1H-pyrrol-2-yl)-N-hydroxy-2-propenamides, a new class of synthetic histone deacetylase inhibitors. J. Med. Chem. 44, 2069-2072.
- Graessle, S., Loidl, P. and Brosch, G. (2001) Histone acetylation: plants and fungi as model systems for the investigation of histone deacetylases. Cell. Mol. Life Sci. 58, 704-720.
- Dangl, M., Brosch, G., Haas, H., Loidl, P. and Lusser, A. (2001) Comparative analysis of HD2 type histone deacetylases in higher plants. Planta 213, 280-285.
- Lechner, T., Carrozza, M.J., Yu, Y., Grant, P.A., Eberharter, A., Vannier, D., Brosch, G., Stillmann, D.J., Shore, D. and Workman, J.L. (2000). Sds3 (Suppressor of Defective Silencing 3) is an integral component of the yeast Sin3/Rpd3 HDAC complex and is required for histone deacetylase activity. J. Biol. Chem. 275, 40961-40969.
- Hoffmann, K., Brosch, G., Loidl, P. and Jung, M. (2000) First non-radioactive assay for in vitro screening of histone deacetylase inhibitors. Pharmazie 55, 601-606.
- Graessle, S., Dangl, M., Haas, H., Mair, K., Trojer, P., Brandtner, E.-M., Walton, J., Loidl, P. and Brosch, G. (2000) Characterization of two putative histone deacetylase genes from Aspergillus nidulans. Biochim. Biophys. Acta 1492, 120-126.
- Lechner, T., Lusser, A., Pipal, A., Brosch, G., Loidl, A., Goralik-Schramel, M., Sendra, R., Wegener, S., Walton, J. and Loidl, P. (2000) Rpd 3 type histone deacetylases in maize embryos. Biochemistry 39, 1683-1692.
- Doetzlhofer, A., Rotheneder, H., Lagger, G., Koranda, M., Kurtev, V., Brosch, G., Wintersberger, E. and Seiser, C. (1999) Histone deacetylase 1 can repress transcription by binding to Sp1. Mol. Cell. Biol., 19, 5504-5511.
- Jung, M., Brosch, G., Kölle, D., Scherf, H., Gerhäuser, C. and Loidl, P. (1999) Amide analogues of Trichostatin A as inhibitors of histone deacetylase and inducers of terminal cell differentiation. J. Med. Chem. 42, 4669-4679.
- Kölle, D., Brosch, G., Lechner, T., Pipal, A., Helliger, W., Taplick, T. and Loidl, P. (1999) Different types of maize histone deacetylases are distinguished by a highly complex substrate- and site-specificity. Biochemistry 38, 6769-6773.
- Hoffmann, K., Brosch, G., Loidl, P. and Jung, M. (1999) A Non-Isotopic Assay for Histone Deacetylase Activity. Nucl. Acids Res. 27, 2057-2058.
- Bauer, A., Mikulits, W., Lagger, G., Stengl, G., Brosch, G. and Beug, H. (1998). The thyroid hormone receptor functions as a ligand-operated developmental switch between proliferation and differentiation of erythroid progenitors. EMBO J. 17, 4291-4303.
- Kölle, D., Brosch, G., Lechner, T., Lusser, A. and Loidl, P. (1998) Biochemical Methods for Analysis of Histone Deacetylases. Methods 15, 323-331.
- Dangl, M., Lusser, A., Brosch, G., Loidl, A., Haas, H. and Loidl, P. (1998) Second Family of Histone Deacetylases. Science 280, 1167.
- Jung, M., Hoffmann, K., Brosch, G. and Loidl, P. (1997) Analogues of Trichostatin A and Trapoxin B as histone deacetylase inhibitors. Bioorg. Med. Chem. Lett. 7, 1655-1658.
- Lusser, A., Brosch, G., Loidl, A., Haas, H. and Loidl, P. (1997) Identification of maize histone deacetylase HD2 as an acidic nucleolar phosphoprotein. Science 277, 88-91.
- Lusser, A., Brosch, G., López-Rodas, G. and Loidl, P. (1997) Histone acetyltransferases during the cell cycle and differentiation of Physarum polycephalum. Eur. J. Cell Biol. 74, 102-110.
- Brosch, G., Lusser, A., Goralik-Schramel, M. and Loidl, P. (1996) Purification and Characterization of a High Molecular Weight Histone Deacetylase Complex (HD2) of Maize Embryos. Biochemistry 35, 15907-15914.
- Brosch, G., Goralik-Schramel, M. and Loidl, P. (1996) Purification of Histone Deacetylase HD1-A of Germinating Maize Embryos. FEBS Lett. 393, 287-291.
- Lechner, T., Lusser, A., Brosch, G., Eberharter, A., Goralik-Schramel, M. and Loidl, P. (1996) A comparative study of histone deacetylases of plant, fungal and vertebrate cells. Biochim. Biophys. Acta 1296, 181-188.
- Brosch, G., Ransom, R., Lechner, T., Walton, J. and Loidl, P. (1995) Inhibition of maize histone deacetylases by HC toxin, the host-selective toxin of Cochliobolus carbonum. Plant Cell 7, 1941-1950.
- Grabher, A., Brosch, G., Sendra, R., Lechner, T., Eberharter, A., Georgieva, E.I., López- Rodas, G., Franco, L., Dietrich, H. and Loidl, P. (1994) Intracellular location of enzymes involved in core histone acetylation. Biochemistry 33, 14887-14895.
- Georgieva, E., López-Rodas, G., Hittmair, A., Feichtinger, H., Brosch, G. and Loidl, P. (1994) Maize embryo germination: I. Cell cycle analysis. Planta 192, 118-124.
- López-Rodas, G., Brosch, G., Georgieva, E.I., Sendra, R., Franco, L. and Loidl, P. (1993) Histone deacetylase – a key enzyme for the binding of regulatory proteins to chromatin. FEBS Lett. 317, 175-180.
- Brosch, G., Georgieva, E., López-Rodas, G., Lindner, H. and Loidl, P. (1992) Specificity of Zea mays Histone Deacetylase Is Regulated by Phosphorylation. J. Biol. Chem. 267, 20561-20564.
- López-Rodas, G., Brosch, G., Golderer, G., Lindner, H., Gröbner, P. and Loidl, P. (1992) Enzymes involved in the dynamic equilibrium of core histone acetylation of Physarum polycephalum. FEBS Lett. 296, 82-86.
- Brosch, G., López-Rodas, G., Golderer, G., Lindner, H., Gröbner, P. and Loidl, P. (1992) Histone acetyltransferases and histone deacetylases of Physarum polycephalum. Cell Biol. Int. Rep. 16, 1103-110



